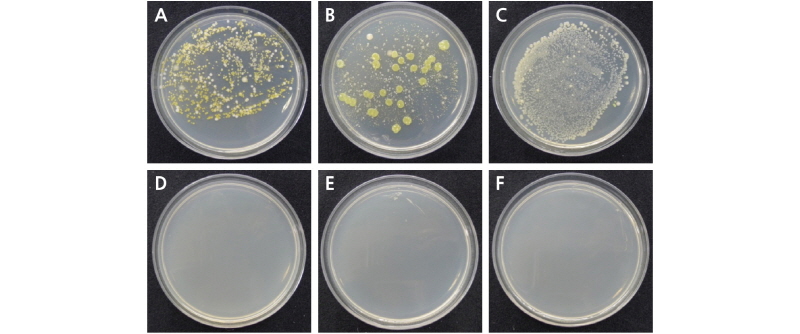
http://static.apub.kr/journalsite/sites/kshs/2018-036-03/N0130360307/images/Figure_HST_36_03_06_F2.jpg

Introduction
Materials and Methods
Plant Materials and Treatments
Measurements and Data Analysis
Experimental Design and Statistical Analysis
Results
Vase Life
Antimicrobial Effect
Discussion
Introduction
Cut rose flowers have a wider and larger number of leaves than other cut flowers (Kim and Lieth, 2012). The effect of growth environment on the vase life of cut roses has been examined mainly by studying stomatal responsiveness because water loss, water stress, and postharvest factors determine the level of water uptake (WU; Fanourakis et al., 2013; In et al., 2016). The vase life of cut rose flowers is determined by the amount of bacteria in the vase solution and in the flower stem (Hoogerwerf et al., 1989), which can block stem xylems as bacterial counts increase above 107 CFU/L in the vase solution (van Doorn et al., 1989). When cut flowers were maintained in water for seven days, the hydraulic conductance was lowest in the basal 5 cm of the stem. This correlated with the maximum bacterial count of 106 CFU/L that induced a low hydraulic conductance and WU (van Doorn et al., 1989).
One of the greatest problems in cut rose flowers is the blockage of vascular system by air or bacterial growth (Van Meetern et al., 2001) that results in early wilting of cut flowers (Henriette and Clerkx, 2001). Adding chemical preservatives to the holding solution is recommended to prolong the vase-life of the cut flowers. All holding solutions must contain essentially two components, sucrose and biocides (Halevy and Mayak, 1981). The exogenous application of sucrose supplies the cut flowers with needed substrates for respiration, which prolongs postharvest life (Pun and Ichimura, 2003). However, bacteria multiply quickly in holding solution where sucrose is exclusively added (Pun and Ichimura, 2003). The vase life of cut flowers was extended by 3% sucrose and 200 mg·L-1 8-hydroxyquinoline sulfate (8-HQS), and the fresh weight of cut flowers in that solution increased compared to that of cut flowers in a control solution of distilled water (DW; Ichimura et al., 1999). Additionally, free chlorine, 8-hydroxyquinoline citrate (8-HQC), 8-HQS, Physan 20TM, benzalkonium chloride, aluminum sulfate, silver nitrate, sodium hypochlorite (NaOCl), dichloroisocyanuric acid (DICA), and other free chlorines can reduce the bacterial count in vase solutions and flower stems, thus extending vase life (Macnish et al., 2008). However, these biocides can be toxic, causing stem browning, leaf abscission, and leaf chlorosis in cut flowers (van Doorn et al., 1990; Knee, 2000).
Therefore, these biocides are rarely used as flower preservatives (Macnish et al., 2008). Higher concentrations of aluminum sulfate, bromopropanediol, dantogard, and thiabendazole were ineffective in increasing vase life, weight gain, and water uptake in the Rosa hybrida L. ‘Classy’ cultivar (Knee, 2000). The continued use of these chemical compounds has raised environmental concerns over the impact these chemical residues have on ecosystems and living organisms (Williamson et al., 2007). Due to human health concerns and environmental pollution, commercial use of 8-HQS, DICA, and NaOCl is limited (Gebhart and Kappauf, 1980), and alternative environmentally friendly compounds are needed (Florack et al., 1996; Chen Z and Zhu C, 2011). It must be shown by scientific studies that follow strict guidelines that the active ingredients and formulated products of biocides are not harmful to humans, nontarget organisms, or the environment (Crespel and Gudin, 2003).
In contrast to the hydrolysis of chlorine gas in water, chlorine dioxide (ClO2, 67.46 g·mol-1) in water does not hydrolyze to any appreciable extent, but remains in solution as a dissolved gas (Junli et al., 1997). Although the electronic structure of the ClO2 molecule is in an unsaturated state, it exists in a monomolecular state in water, which is very favorable for its rapid diffusion (Macnish et al., 2008). It is readily decomposed by light, but stable in the dark in water for several months (Junli et al., 1997). Moreover, ClO2 does not react with nitrogen-containing compounds, organic compounds (i.e. carcinogenic chemicals), or ammonia to form dangerous chlorine compounds (Karabulut et al., 2009). Furthermore, it does not lead to the formation of trihalometanes (THMs) or other hazardous chemical compounds, such as haloacetic acids (HAAs) and haloacetonitriles (HANs; Bellar et al., 1974). The US Food and Drug Administration (FDA, 1998), and the Korean government (Ministry for Food, Agriculture, Forestry and Fisheries, 2010) have allowed the use of aqueous ClO2 in washing fruits and vegetables (EU, 2004). There are numerous reports in the literature describing the beneficial effects of ClO2 treatments on fruits and vegetables. However, very few reports describing the use of ClO2 on cut flowers exist. Tap water (TW) containing 5 µL·L-1 of ClO2 extended the vase life of roses by three days compared to TW alone (Koermer and Wldman, 2002). It has been reported that 2 µL·L-1 to 10 µL·L-1 ClO2 can also extend the vase lifeof Alstroemeria ‘Senna,’ Antirrhinum ‘Potomic Pink,’ Gerbera ‘Lorca,’ Gypsophila ‘Perfecta,’ and Rosa ‘Charlotte’ (Macnish et al., 2008). The effect of ClO2 on extending the longevity of cut Gerbera flowers was similar to that of 8-HQS and was more effective than other biocides, such as aluminum sulfate, DICA, Physan 20TM, and sodium hypochlorite (Macnish et al., 2008). A holding solution treatment of 10 µL·L-1 ClO2 extended the longevity of Gerbera flowers more than a pulsing treatment (Macnish et al., 2008). The objective of this study was to examine the possibility of using ClO2 with sucrose in cut rose flowers.
Materials and Methods
Plant Materials and Treatments
Cut rose (Rosa hybrida L.) flowers of the ‘Beast’ cultivar were harvested at the commercial harvest phase (Kumar et al., 2008) from a greenhouse in Paju, Korea. Stems were hydrated under tap water (TW) and transported within one hour to the postharvest laboratory at the University of Seoul. In the laboratory, the stems were re-cut under distilled water (DW) to a length of 40 cm, and all except three leaves were removed. Cut roses with a stem diameter in the range of 7-9 mm were used. ClO2 (CA-200, PurgoFarm Inc., Korea) was used with DW. Individual cut flowers were kept in vases containing holding solutions (400 mL) of TW, DW, and 2% sucrose, 2% sucrose with 2 µL·L-1 ClO2, 2% sucrose with 4 µL·L-1 ClO2, 2% sucrose with 6 µL·L-1 ClO2, and 2% sucrose with 8 µL·L-1 ClO2 in DW. The room temperature was 19.4°C, relative air humidity was 58.4%, and photosynthetically active radiation was 8.7 µmol·m-2·s-1, set to a 12 hour photoperiod.
Measurements and Data Analysis
Assessment of vase life was performed daily according to the evaluation criteria reported by Macnish et al. (2008) and Fanourakis et al. (2013) with slight modifications. Cut flowers were determined to have reached the end of their vase life when one of the following senescence symptoms was detected: wilting (50% turgor loss in petals or leaves), bluing (50% blue petals), abscission (drop of one petal or leaf), and bending (30° more bent peduncle). The relative fresh weight (RFW, %) and vase solution uptake (mL·d-1·g-1FW) were calculated every two days using the formula developed by Chamani and Esmaeilpour (2007). The chlorophyll content in 0.1 g of leaves was extracted using 10 mL 100% methanol from cut leaf segments on day six. The absorbance of the extracts was determined with a UV spectrophotometer (UV-2450, Shimadzu, Kyoto, Japan; Arnon, 1949). Three replicates were conducted for each measurement.
The concentrations of ClO2 were measured with Chlorine Dioxide HI 93738 ISM (Hanna Instruments Inc., USA) and the Chlorine Dioxide Insta-Test (Lamotte Instruments Inc., USA). The concentrations of ClO2 in the treatments were consistent with nontoxic levels (Macnish et al., 2008). The total number of aerobic bacteria in vase solutions was determined by collecting 1.0 mL samples from each vase and serially diluting each sample 101-106 fold in sterile DW. Aliquots (0.1 mL) of the diluted samples were pipetted onto agar plates (NA, DifcoTM) and the bacteria plates were incubated for three days at 28°C, after which the bacterial count was recorded as CFU/L (van Doorn et al., 1989; van Doorn et al., 1990).
Experimental Design and Statistical Analysis
The vase life experiments followed a completely randomized block design with ten replicates for each experiment. Statistical Analysis System (SAS) version 9.4 (SAS Institute Inc., Cary, NC, USA) was used to analyze the experimental data for multiple comparisons via analysis of variance (ANOVA). Differences between the means from the treatments were assessed with Duncan’s New Multiple Range Test (DMRT) at p ≤ 0.05.
Results
Vase Life
The vase life of the cut roses was maximized in the 2% sucrose solution that included 4 µL·L-1 ClO2, and was extended four days longer than the TW and DW solutions alone (Table 1). Indeed, the 2% sucrose treatments with 4 µL·L-1, 6 µL·L-1, and 8 µL·L-1 ClO2 significantly extended the vase life of the cut rose flowers. The vase life was shortest under the 2% sucrose treatment (4.4 d) compared to the TW (6.9 d) or DW (6.6 d) treatments. Although statistical analyses of pigment content did not produce any significant results, the chlorophyll and carotenoid content in cut rose leaves were reduced in the 2% sucrose treatment, and leaf yellowing was observed after two days. In particular, the chlorophyll b content in leaves was reduced in the 2% sucrose treatment compared to the TW treatment (Table 2). The RFW of cut roses under all treatments except the sucrose treatment alone increased from the initial RFW (100%) for six days and then gradually decreased (Fig. 1A). The RFW of cut roses under 2% sucrose treatments with 4 µL·L-1, 6 µL·L-1, and 8 µL·L-1 ClO2 had a longer vase life that was higher than the other treatments on day six. Moreover, the RFW of the 2% sucrose and TW treatments dramatically decreased after day six. The vase solution uptake in all treatments except the sucrose alone treatment increased to peak uptake on day six and then decreased (Fig. 1B), while the vase solution uptake in the 2% sucrose treatment constantly decreased throughout the whole treatment duration. The vase solution uptake of cut roses in the 2% sucrose treatment with 2 µL·L-1 ClO2 sharply decreased after day 10 (Fig. 1B).

Fig. 1. Effects of sucrose supplemented with chlorine dioxide (ClO2) on relative fresh weight (A) and solution uptake (B) of cut rose ‘Beast’ flowers during their vase life. T1: tap water (TW), T2: distilled water (DW), T3: 2% sucrose, T4: 2% sucrose + 2 µL·L-1 ClO2, T5: 2% sucrose + 4 µL·L-1 ClO2, T6: 2% sucrose + 6 µL·L-1 ClO2, T7: 2% sucrose + 8 µL·L-1 ClO2 holding solutions. The test room conditions were controlled as air temperature at 19.4°C, relative humidity at 58.4%, and light intensity at 8.7 µmol·m-2·s-1 PAR with a 12 hour photoperiod. Vertical bars indicate standard error (n = 10).
Antimicrobial Effect
To identify the antimicrobial effect of ClO2, bacterial counts were examined on day six, which was the vase life termination for the control. In the TW, DW, and 2% sucrose treatments without ClO2, bacteria were detected in the solutions at counts of 2.3×105 CFU/L, 4.8×105 CFU/L,and 2.4×106 CFU/L, respectively; the highest bacterial count was observed in the 2% sucrose solution. In contrast, the sucrose treatments with 2 µL·L-1, 4 µL·L-1, 6 µL·L-1, and 8 µL·L-1 ClO2 in the holding solution showed effective bacterial inhibition, with no bacteria detected on the sixth day after harvest (Table 3 and Fig. 2).
Fig. 2. Colony formation of bacteria isolated from different holding solutions of cut rose ‘Beast’ flowers on day six after chlorine dioxide treatment. The samples taken from the vase solutions were incubated for three days at 28°C. Culture plates from A: Tap water (TW), B: distilled water (DW), C: 2% sucrose, D: 2% sucrose + 2 µL·L-1 ClO2, E: 2% sucrose + 4 µL·L-1 ClO2, and F: 2% sucrose + 8 µL·L-1 ClO2 holding solutions (n = 3).
Discussion
The 2% sucrose treatments with 4 µL·L-1 to 8 µL·L-1 ClO2 extended the vase life of cut rose flowers compared to the control holding solutions (TW and DW). The 2% sucrose treatment supplemented with 4 µL·L-1 ClO2 had the longest vase life (Table 1). In aqueous solutions, 100% of the ClO2 exists in a molecular state, where it has contact with the bacterial surface and can permeate through the cell membrane into the bacterial body (Junli et al., 1997). Due to the semipermeability of the membrane, the permeation pressure of the membrane is destroyed and the bacteria are killed (Junli et al., 1997). A vase solution treatment of 2 µL·L-1 ClO2 significantly extended the vase life of Gerbera ‘Monarch,’ Gypsophila ‘Crystal,’ and Matthiola ‘Ruby Red’ cut flowers, whereas did not significantly extend that of Rosa hybrida ‘Charlotte’ (Macnish et al., 2008). A vase solution treatment that included 2% sucrose and ClO2 was more effective than sucrose treatment alone, as sucrose treatment was ineffective and caused leaf yellowing from day two, and ultimately shortening the vase life (Tables 1 and 2).
Skutinik et al. (2001) showed that a sucrose-containing preservative dramatically reduced the vase life and decreased the chlorophyll content in Zantedeschia aethiopica leaves. The chlorophyll content of cut flowers treated with a combination of biocide and sucrose increased compared to those treated with a biocide alone (Asrar, 2012); however, a ClO2 supplement in the vase solution did not produce leaf yellowing. The application of a 2% sucrose treatment with 4 µL·L-1 ClO2 increased the vase life as well as the RFW; a ClO2 treatment would prevent the growth of microorganisms in the xylem and therefore, maintain water uptake in the flower stem (Tables 1 and 3, Fig. 1). However, the sucrose treatment alone reduced vase solution uptake and RFW, and consequently impaired the vase life in rose flowers (Tables 1 and 3, Fig. 1B). In addition, the highest microbial growth was observed in the sucrose alone treatment, which indicates that sucrose promoted microbial growth in the vase, consistent with previous reports (Halevy and Mayak, 1981).
The vase life of cut rose flowers is primarily influenced by water balance, which is determined by water loss and water uptake (Fanourakis et al., 2013). Bacteria in vase solutions were detected in the TW, DW, and 2% sucrose treatments, but not in the 2% sucrose solutions supplemented with 2 - 8 µL·L-1 ClO2 (Table 3). This result was similar to a previous study that detected bacteria in cut rose flowers placed in DW and TW (Kim et al., 1997). Macnish et al. (2008) reported that the inclusion of 10 µL·L-1 ClO2in a vase solutionprevented the visible accumulation of bacteria on cut stem surfaces of Rosa ‘Charlotte’ during the first three days of vase life. The vascular blockage in Rosa hybrida ‘Norena’ can be caused by Pseudomonas fluorescens, Klebsiella oxytoca, and Aeromonas hydrophila, which were isolated on the cut stem vasculature; furthermore, bacterial concentrations of 1× 105 CFU/L in vase solutions caused bent-neck symptoms in cut rose flowers (Kim et al., 1997). In this study, bacteria were not detected in holding solution treatments of sucrose supplemented 2 µL·L-1 to 8 µL·L-1 ClO2 after six days, although the initial ClO2 content in the all ClO2-supplemented holding solutions was completely depleted on after two days of treatment, which was similar to results of a previous chlorine dioxide study (Lee and Kim, 2014). This result indicates that sterilization of holding solutions with ClO2 at the initial postharvest stage is enough to inhibit microbial proliferation in the holding solution during vase life. In other words, ClO2 was consumed in the early days of treatment with sucrose holding solutions, but its sterilization effect lasted longer than six days. In conclusion, the sucrose and ClO2 holding solutions had a synergistic effect on vase life that is attributed to the suppression of microbial growth, which in turn increased water uptake, delayed leaf yellowing in cut rose flowers.





